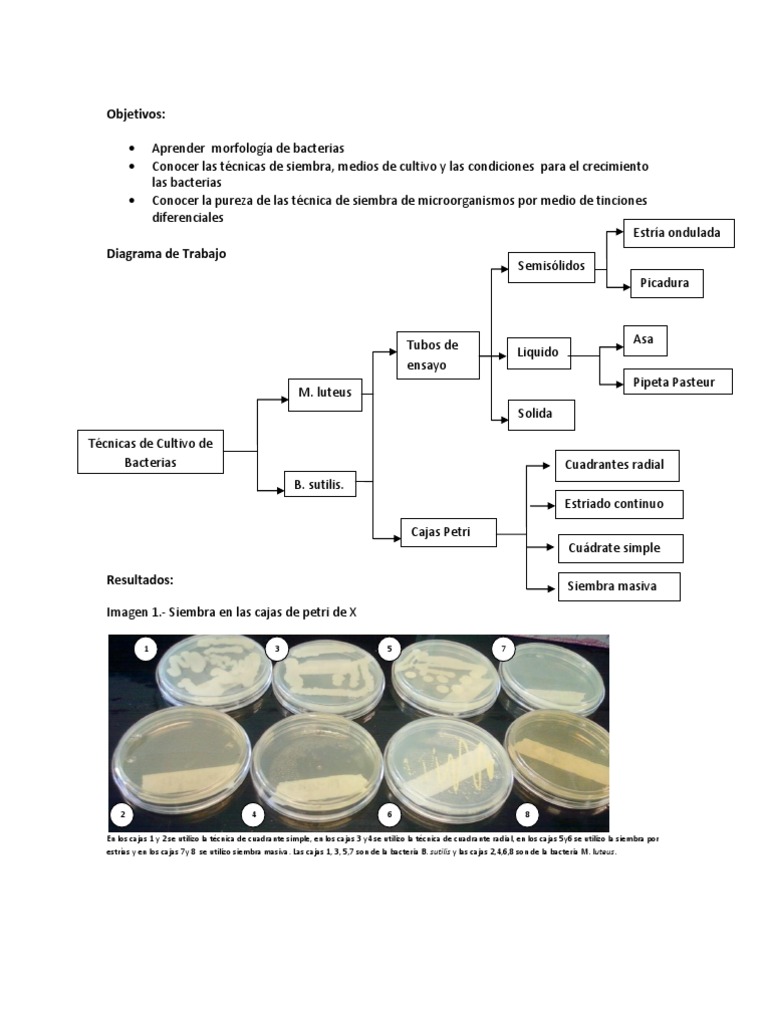

técnicas de cultivo y siembra de Bacterias Tinción Microbiología
Los medios de cultivo son mezclas de sustancias que promueven el crecimiento y diferenciación de los microorganismos. Estos medios contienen nutrientes, fuentes de energía, minerales etc. Se pueden clasificar de diferentes maneras como son por su consistencia (sólidos, líquidos, semisólidos), su origen (naturales, sintéticos.
Preparación de medios de cultivo qué son, objetivos, tipos, pasos

Siembra en cajas de Petri con espátula de Drigalsky. Con pipeta estéril colocar 0,1 ml del inóculo sobre las placas de agar nutritivo (hacerlo por triplicado), diseminar inmediatamente con espátula de vidrio o metálica esterilizada a la llama del mechero.
Medios de cultivo, paso clave en la identificación de Behner SAS

Práctica 1, 2, 3: Medios de cultivo. Isabela Garcia Huergo, Jenyfer Jezabel Hernàndez Ramos, Javier Àvila Cedillo, Irving Jacob Gonzalez Castañeda, Daniela Ivette Luna Carrasco Asignatura: Microbiología.
Practicas de BIOQUIMICA y MICROBIOLOGIA por Mª Jesus Ibarra Cabezas Preparación de medios de
Figura 4.2.4 4.2. 4: (CC-BY; Este libero) Esta técnica permite sembrar inóculos sobre superficies grandes, para obtener un crecimiento confluente que nos permite estudiar el efecto de antimicrobianos (antibióticos, antisépticos, desinfectantes, etc.). También se utiliza para realizar recuento de colonias; para cumplir con este último.
Medios De Cultivo

4.3: Cultivos en medios líquidos. Page ID. María M. Reynoso, Carina E. Magnoli, Germán G. Barros y Mirta S. Demo. Universidad Nacional de Río Cuarto. Índice. Sin encabezados. Se lleva el material con ansa en anillo o pipeta a un recipiente (frasco Erlenmeyer o tubo) conteniendo el medio de cultivo líquido. Generalmente este tipo de.
Medios de Cultivo de M.Strempler Candida albicans, Candida

Los Medios de Cultivo son preparados estériles que contienen sustancias necesarias para el desarrollo de los microorganismos. Todos los microorganismos requieren agua, carbono, nitrógeno, hidrógeno, calcio, fósforo y hierro como elementos vitales. Los microorganismos exigentes requieren además factores de crecimiento como aminoácidos.
Técnicas básicas de Microbiología Preparación de Placas de Petri con medio de cultivo. YouTube

Historia. El primer medio de cultivo fue preparado por Louis Pasteur cuando intentaba demostrar que la vida microbiana no era producto de la generación espontánea, sino que los microorganismos se podían multiplicar y además que provenían del aire. El preparó un caldo con trozos de carne y observó que al cabo de unos días después de.
4.2 Cultivos en medios sólidos LibreTexts Español

Cualquier componente montado se puede reemplazar, incluido un subconjunto, un miembro de un grupo o una FDU. Se puede reemplazar más de un componente a la vez en un conjunto. Es posible reemplazar varias apariciones de un componente por un único componente o varios componentes pueden ser reemplazados por distintos componentes individuales.
Medios De Cultivo

1.10. Agar manitol sal. El agar manitol sal, también conocido como manitol salado, es un medio de cultivo sólido que sigue siendo utilizado para el aislamiento de "Staphylococcus aureus", aunque en este caso el poder inhibitorio sobre el resto de bacterias es más fuerte. Es decir, es más selectivo que el anterior.
PPT MEDIOS DE CULTIVO Para TP N° 1 Microbiología e Inmunología Parte A Lic. en Biol. Mol

Informe medio de cultivo informe de practica de laboratorio: medios de cultivo. resumen. inicialmente se realizó una explicación breve sobre los diferentes
Tabla De Medios De Cultivo Microbiologia Ciencias De La Tierra Y De Images

%PDF-1.7 %âãÏÓ 717 0 obj > endobj xref 717 24 0000000016 00000 n 0000007016 00000 n 0000007238 00000 n 0000007274 00000 n 0000007707 00000 n 0000008476 00000 n 0000009151 00000 n 0000009188 00000 n 0000009302 00000 n 0000009881 00000 n 0000010527 00000 n 0000010904 00000 n 0000011375 00000 n 0000013221 00000 n 0000014968 00000 n 0000016690 00000 n 0000018467 00000 n 0000020159 00000 n.
MEDIOS DE CULTIVO Y TCNICAS DE AISLAMIENTO Microbiologa

Última edición el 17 de marzo de 2022 . La preparación de medios de cultivos es una metodología de rutina usada en los laboratorios para el crecimiento de microorganismos deseados. Los medios de cultivo son preparaciones sólidas, líquidas o semi-sólidas que poseen todos los nutrientes necesarios para el desarrollo de una población.
Joseph Banks Decano Mantenimiento importancia de los medios de cultivo en microbiologia Ninguna

Las actividades metabólicas de la población microbiana en crecimiento, llegarán a cambiar el medio ambiente hasta hacerlo muy desfavorable (acumulación de metabolitos orgánicos tóxicos, agotamiento del oxígeno, cambio de pH). Tabla 3.6.1 3.6. 1 :Los medios de cultivos se clasifican en: Clasificación. Definición. Características.
microbiologia MEDIOS DE CULTIVO

Caldo lactosado bilis verde brillante en donde la bilis inhibe el crecimiento de bacterias gram positivas. En Advance, tenemos varios de estos medios de cultivo deshidratados, como 3M - Base de Agar Baird-Parker, 3M - Caldo Lactosado, 3M - Agar de Bilis Rojo Violeta y 3M - Caldo de Infusión de Cerebro y Corazón.
Microbiología RESIEMBRA DE MEDIOS DE CULTIVO

El cultivo es el proceso de proliferación de microorganismos al proporcionarles un entorno apropiado. Los microorganismos en proliferación producen réplicas de sí mismos y necesitan los elementos presentes en su composición química. Los nutrientes deben proporcionar estos elementos en una forma que sea accesible desde el punto de vista.
Microbiología e Higiene Alimentaria 23. Preparación de medios de cultivo

1. Preparar medios de cultivo como soporte y fuente de nutrientes para el desarrollo de los microorganismos in vitro. 2. Manejar los instrumentos de uso rutinario, a la vez que imprescindibles, en el laboratorio de microbiología. 3. Hacer un primer acercamiento a la manipulación de microorganismos.
.